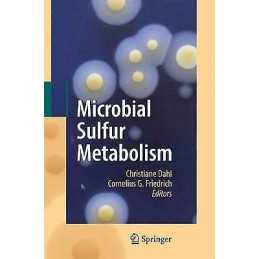
Microbial Sulfur Metabolism - 9783642091735

Impact Spectropolarimetric Sensing - 9780306458927
Jaunums: Jauna, nelasīta, nelietota grāmata ideālā stāvoklī, bez iztrūkstošām vai bojātām lapām. Skatīt ... Lasīt vairāk par stāvokliJaunums: Jauna, nelasīta, nelietota grāmata ideālā stāvoklī, bez trūkstošām vai bojātām lapām. Lai iegūtu pilnu informāciju, skatiet pārdevēja sarakstu. Skatīt visas nosacījumu definīcijas tiek atvērtas jaunā logā vai cilnē
242,25 €